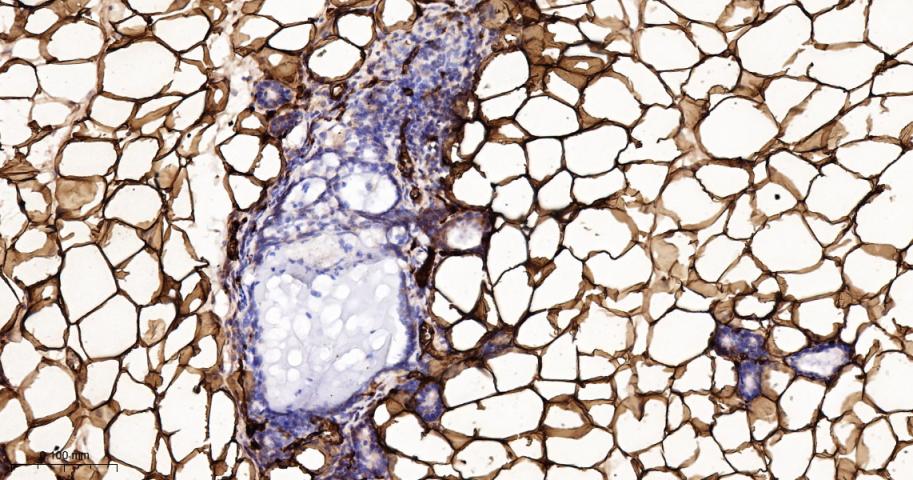
脂肪细胞型脂肪酸结合蛋白4重组兔单抗

Cancer > Cancer Metabolism > Metabolic signaling pathway > Metabolism of lipids and lipoproteins
Cardiovascular > Lipids / Lipoproteins > Fatty Acids > Binding proteins
Cardiovascular > Lipids / Lipoproteins > Fatty Acids > Metabolism
Metabolism > Pathways and Processes > Metabolic signaling pathways > Lipid and lipoprotein metabolism > Fatty acids
Metabolism > Pathways and Processes > Metabolic signaling pathways > Lipid and lipoprotein metabolism > Lipid metabolism
Metabolism > Pathways and Processes > Redox metabolism > Fatty acid oxidation
Metabolism > Types of disease > Cancer
FABP4 encodes the fatty acid binding protein found in adipocytes. Fatty acid binding proteins are a family of small, highly conserved, cytoplasmic proteins that bind long-chain fatty acids and other hydrophobic ligands. It is thought that FABPs roles include fatty acid uptake, transport, and metabolism. [provided by RefSeq].

| 应用 | 已检合格种属 | 预测种属 | 推荐稀释比例 |
|---|---|---|---|
| WB | Mouse, Rat | Human | 1:500-2000 |
| IHC-P | Human, Mouse, Rat | 1:100-500 | |
| IHC-F | Human, Mouse, Rat | 1:100-500 | |
| IF | Human, Mouse, Rat | 1:100-500 |
交叉反应: Human, Mouse, Rat
暂无相关产品